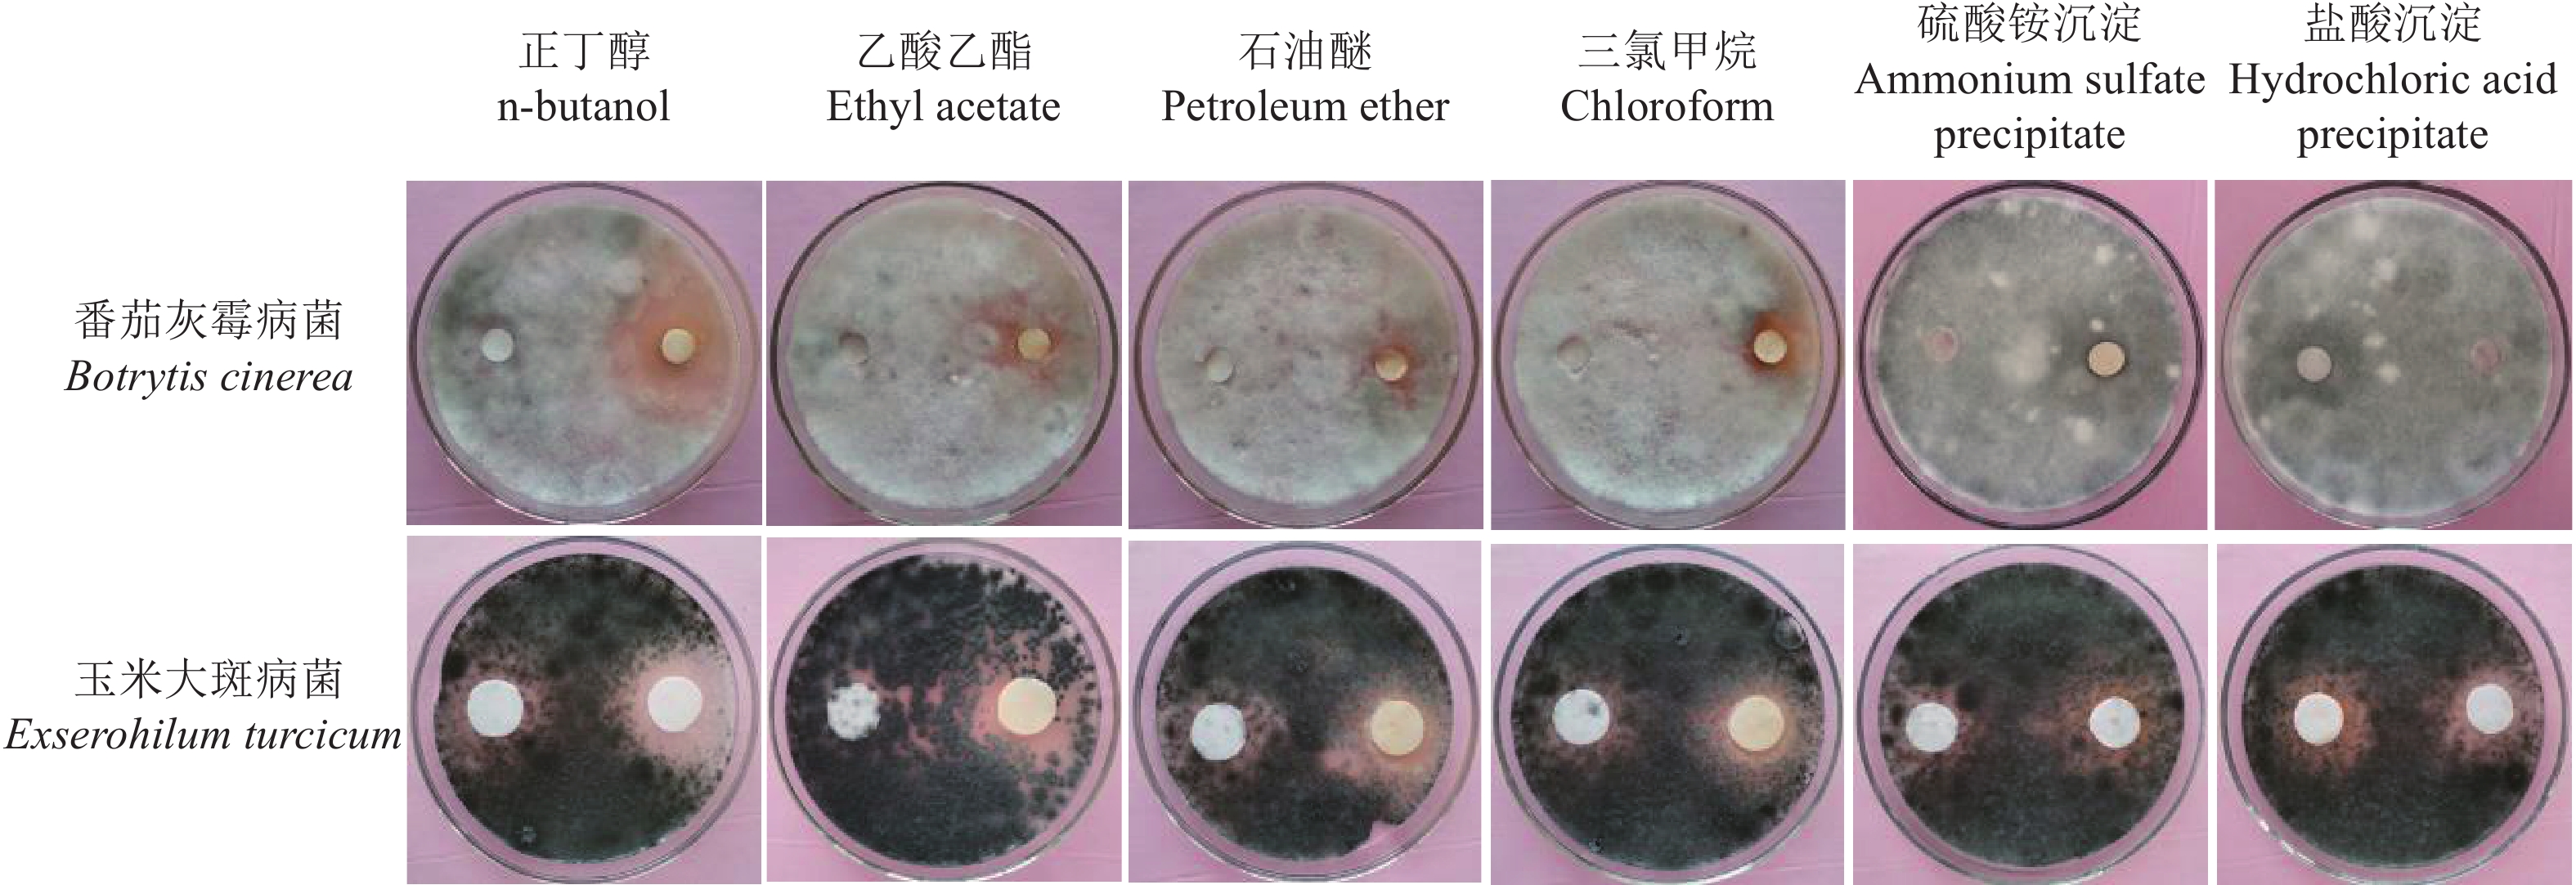

真菌是植物病害生物防治的重要组成部分。子囊菌门毛壳菌属Chaetomium Kunze的球毛壳C. globosum、角毛壳C. cupreum[1]、螺旋毛壳C. spirale[2]和金色毛壳C. aureum[3]对植物病害具有较好的防治作用,该属的真菌可通过生存竞争、重寄生、产生抑菌物质、促生和诱导抗病性等方式发挥生防作用[4-5],其中,产生抑菌物质是其重要的作用方式[6-10]。
生防菌产生的抑菌物质可存在于菌体细胞内,也能分泌到菌体细胞外发挥生防作用。存在于细胞内的抑菌物质可通过菌体超声或研磨破碎提取,然后进行抑菌活性检测;产生于菌体外的抑菌物质则可通过对菌体培养液的抑菌活性进行检测分析[11-12]。生防菌产生的胞外抑菌物质有挥发性和非挥发性的。挥发性抑菌物质通常采用平板密封培养法检测,而非挥发性抑菌物质则可通过培养液的盐析沉淀、酸沉淀、有机溶剂萃取等途径获得[13-14]。
不同生防菌产生的抑菌物质不同,有效提取方法也不同。许乐等[15]通过硫酸铵沉淀、盐酸沉淀法提取了多黏类芽孢杆菌Paenibacillus polymyxa DS-R5中的抑菌物质,结果发现其培养液的硫酸铵沉淀物无抑菌活性,但盐酸沉淀物对腐皮镰刀菌Fusarium solani孢子萌发有明显抑制作用。杨廷雅等[16]发现,短短芽孢杆菌Brevibacillus brevs HAB-5培养液的硫酸铵沉淀、有机溶剂(石油醚、氯仿、乙醚、乙酸乙酯和正丁醇)萃取物均无明显抑菌活性,但有机溶剂萃取后的水相部分对炭疽病菌Colletotrichum gloeosporioides Penz C7-2有较高的抑菌活性。Phong等[17]和Yan等[18]通过甲醇、正己烷和乙酸乙酯萃取,分别从球毛壳菌株CG05和CDW7中获得了抑菌活性物质。
菌株LB-1是我们从龙柏鳞叶小枝中分离的1株近缘毛壳C. subaffine生防菌,前期研究发现,菌株LB-1对玉米大斑病菌Exserohilum turcicum、番茄灰霉病菌Botrytis cinerea和玉米小斑病菌Bipolaris maydis等多种植物病原菌有拮抗作用,其拮抗作用与产生的抑菌物质密切相关[19],但目前鲜见近缘毛壳抑菌物质的研究报道。基于此,本研究拟对菌株LB-1抑菌物质存在部位及提取方法进行分析,以期为菌株LB-1防治植物病害研究提供科学依据。
1 材料与方法 1.1 供试材料近缘毛壳C. subaffine菌株LB-1、番茄灰霉病菌B. cinerea、玉米大斑病菌E. turcicum均为潍坊学院园林实验室保存的菌种。
马铃薯葡萄糖琼脂(Potato dextrose agar,PDA)培养基用于菌株LB-1和2种供试植物病原真菌的活化以及菌株LB-1抑菌物质的检测,其配方为:去皮土豆200 g、葡萄糖20 g、琼脂粉17~20 g,蒸馏水1000 mL;马铃薯葡萄糖(Potato dextrose broth,PDB)培养液用于菌株LB-1的液态培养。PDA培养基和PDB培养液用高压灭菌(121 ℃、20 min)。
1.2 菌株LB-1产生的抑菌物质及存在部位 1.2.1 菌体胞内抑菌物质的检测方法参照梁建根等[12]的方法,将在PDA平板上培养3 d的菌株LB-1的菌丝用8.5 g/L NaCl溶液冲洗、悬浮,−20 ℃条件下保存24 h,然后超声破碎处理30 min,破碎液在4 ℃、12000 r/min离心20 min,上清液即为菌体胞内提取物。
参照罗琳等[20]的含毒培养基法检测菌体胞内提取物的抑菌作用。将菌株LB-1胞内提取物用0.22 μm的微孔滤膜过滤,然后以体积比1∶3的比例加入PDA培养基,制成含菌株LB-1胞内提取物的PDA平板;接种供试病原菌菌饼(直径6 mm)于平板中央,置于光照培养箱中培养(25 ℃、自然光照) 6 d,测定菌落直径,并计算抑制率。对照培养基平板中加入与处理等量的8.5 g/L NaCl溶液。对照和处理各设3次重复。
1.2.2 菌体胞外抑菌物质的检测方法将在PDA平板上培养3 d的菌株LB-1的菌饼(直径6 mm)接种至灭菌后的50 mL PDB培养液中,振荡培养(25 ℃、130 r/min) 3、7、10、15、20 d后,培养液用2层纱布过滤,滤液在4 ℃、12000 r/min条件下离心20 min,上清液即为无菌体培养液。采用“1.2.1”的含毒培养基法检测不同培养天数培养液的抑菌活性,以正常PDA培养基为对照。
参照Landum等[13]的平板密封培养法检测菌株LB-1是否产生挥发性抑菌物质。用打孔器获取在PDA培养基上培养3 d的菌株LB-1、番茄灰霉病菌和玉米大斑病菌菌饼(直径6 mm),接种在新制备的PDA平板中央,置于光照培养箱中培养2 d(25 ℃、自然光照),然后把含有菌株LB-1菌饼的培养皿分别与含有2种供试病原菌菌饼的培养皿底部对扣、密封,继续培养5 d,观察病原菌生长情况,测量处理和对照培养皿中病原菌菌落直径,并计算抑制率。对照为病原菌菌饼单独培养。对照和处理各设3次重复。
1.3 菌株LB-1培养液中的抑菌物质提取方法 1.3.1 盐析沉淀参照周瑚等[21]的方法,将在PDB培养基中25 ℃、130 r/min振荡培养15 d的菌株LB-1培养液用2层纱布过滤,滤液在4 ℃、12000 r/min条件下离心20 min,获得无菌体培养液。在培养液中加入硫酸铵至80%饱和度,振荡混匀,4 ℃静置48 h,然后4 ℃、12000 r/min离心20 min,沉淀物用PBS缓冲液溶解、定容,获得硫酸铵沉淀物溶液。
1.3.2 酸沉淀参照梁建根等[12]的方法,将菌株LB-1的培养液(培养方法同“1.3.1”),用1 mol/L盐酸溶液将pH调至3~4,4 ℃静置过夜,然后在4 ℃、12000 r/min条件下离心20 min,沉淀物用50 mmol/L磷酸缓冲液(pH=7.0)溶解、定容,获得盐酸沉淀物溶液。
1.3.3 有机溶剂提取参照马桂珍等[22]的方法,将菌株LB-1的培养液(培养方法同“1.3.1”)分别与等体积的正丁醇、乙酸乙酯、石油醚、三氯甲烷混匀,静置30 min,收集水相和有机相;水相用旋转蒸发器蒸发、浓缩10倍后备用;有机相旋转蒸发,蒸干提取物用二甲基亚枫(Dimethylsulfoxide,DMSO)溶解、定容,获得有机相粗提物溶液。
1.3.4 抑菌效果检测含毒培养基法检测:将菌株LB-1培养液的硫酸铵沉淀、盐酸沉淀、有机相粗提物和水相浓缩液分别加入PDA培养基中(水相浓缩液以体积比1∶3的比例加入,硫酸铵沉淀、盐酸沉淀和有机相粗提物在PDA平板中的质量浓度均为0.1 mg/mL),制成含有不同提取物的PDA平板,在平板中央分别接种供试番茄灰霉病菌和玉米大斑病菌菌饼,置于光照培养箱中培养6 d(25 ℃、自然光照),测量病原菌菌落直径,并计算抑制率。为消除不同提取物溶剂的干扰,设PBS缓冲液、磷酸缓冲液和DMSO以及正常PDA平板为对照。处理和对照各设置3次重复。
滤纸片法复检:分别将番茄灰霉病菌和玉米大斑病菌菌悬液0.3 mL均匀地涂抹在PDA平板上,然后将直径6 mm的滤纸片分别放置于含菌PDA平板中轴两端的相对位置,一端滤纸片中分别加入100 μL 0.1 mg/mL的LB-1菌株培养液的硫酸铵沉淀物溶液、盐酸沉淀物溶液和有机溶剂粗提物,另一端滤纸片分别加入100 μL溶解硫酸铵沉淀物的PBS缓冲液、溶解盐酸沉淀物的溶剂磷酸缓冲液以及溶解4种有机溶剂粗提物的溶剂DMSO,然后置于光照培养箱中培养(25 ℃、自然光照),3 d后观察滤纸片周围菌落生长情况。每种处理设置3个重复。
1.4 数据分析数据采用SAS 8.1软件进行统计分析,应用最小显著差异法(Least significant difference,LSD)进行差异显著性检验。
| $ 抑制率 = (D_{对照}-D_{处理})/D_{对照} \times 100{\text{%}}, $ |
式中,D处理、D对照分别表示处理和对照病原菌菌落的直径,mm。
2 结果与分析 2.1 菌株LB-1产生的抑菌物质及其存在的部位近缘毛壳LB-1菌丝超声破碎提取物对供试番茄灰霉病菌和玉米大斑病菌生长的抑制作用与8.5g/L NaCl溶液相当(表1),表明LB-1菌体胞内提取物无抑菌作用,说明菌株LB-1产生的抑菌物质不在菌体细胞内。
|
|
表 1 菌株LB-1菌体胞内提取物质对病原菌生长的抑制效果 Table 1 Inhibitory effects of intracellular extract of strain LB-1 on the growth of plant pathogens |
菌株LB-1在PDB培养液中振荡培养不同天数的胞外培养液对2种供试植物病原真菌的生长均有抑制作用,且随着培养天数的增加,其抑菌率不断增加,但培养15 d后的抑菌率与培养20 d的无显著差异(表2),表明菌株LB-1产生的抑菌物质存在于菌体胞外的培养液中。
|
|
表 2 菌株LB-1不同培养天数的培养液对病原菌生长的抑制效果 Table 2 Inhibitory effects of culture broth of strain LB-1 on the growth of plant pathogens |
平板密封培养发现,2种供试病原菌和菌株LB-1对扣共培养的菌落直径与病原菌单独培养的菌落直径之间无明显差异。番茄灰霉病菌单独培养的菌落直径为60.17 mm,与菌株LB-1共培养的菌落直径为59.00 mm;玉米大斑病菌单独培养的菌落直径为67.17 mm,与菌株LB-1共培养的菌落直径为65.00 mm。这表明菌株LB-1不产生挥发性的抑菌物质。
2.2 菌株LB-1培养液粗提物的抑菌效果 2.2.1 盐析沉淀、酸沉淀提取物的抑菌效果含毒培养基法检测发现,硫酸铵和盐酸提取菌株LB-1培养液获得的沉淀物(质量浓度0.1 mg/mL)对供试的2种病原菌生长的抑制效果与缓冲液的相当(表3),表明盐析沉淀、酸沉淀不能有效提取菌株LB-1培养液中的抑菌物质。
|
|
表 3 菌株LB-1培养液的硫酸铵沉淀物和盐酸沉淀物对病原菌生长的抑制效果 Table 3 Inhibitory effects of ammonium sulfate precipitation and hydrochloric acid precipitation of culture broth of strain LB-1 on the growth of plant pathogens |
含毒培养基法检测发现,菌株LB-1在PDB中振荡培养15 d获得的培养液通过正丁醇、乙酸乙酯、石油醚和三氯甲烷萃取后,其水相浓缩液对供试番茄灰霉病菌和玉米大斑病菌的生长无明显抑制效果,但0.1 mg/mL的正丁醇、乙酸乙酯、石油醚和三氯甲烷萃取物对2种病原真菌的生长有抑制作用,抑制效果最好的是正丁醇萃取物,对番茄灰霉病菌和玉米大斑病菌生长的抑制率分别高达59.80%和58.37%,而其余3种有机溶剂萃取物的抑菌率较小(表4)。
|
|
表 4 菌株LB-1培养液的有机溶剂萃取物及水相对病原菌生长的抑制效果 Table 4 Inhibitory effects of organic extracts and its aqueous phase of culture broth of strain LB-1 on the growth of plant pathogens |
菌株LB-1培养液的硫酸铵沉淀物、盐酸沉淀物和有机溶剂萃取物,其抑菌活性的滤纸片法复检结果与含毒培养基法检测结果相似,在含有硫酸铵沉淀物、盐酸沉淀物的滤纸片周围无透明区域,而在含有有机溶剂萃取物的滤纸片周围有不同程度的透明区域,其中以正丁醇萃取物的透明区域表现最为明显(图1),表明菌株LB-1培养液中的抑菌物质可通过有机溶剂萃取,正丁醇是萃取菌株LB-1培养液抑菌物质的最佳有机溶剂。
|
图 1 滤纸片法检测的菌株 LB-1 培养液不同提取物对病原菌生长的抑制效果 Fig. 1 Antifungal effects of different extracts from culture broth of strain LB-1 on the growth of plant pathogens by filter paper disc assay 每一培养皿中,左侧滤纸片为 DMSO 或缓冲液处理(CK),右侧为有机溶剂萃取物或沉淀物处理 In each petri dish, the filter paper on the left side was treated with DMSO or buffer solution (CK), the right side was treated with organic extract or precipitation |
赵德立等[11]、梁建根等[12]通过菌体超声破碎提取、培养液盐析沉淀和有机溶剂萃取研究芽孢杆菌菌株BH-2和JW-725产生的抑菌物质,结果发现这些菌株产生的抑菌物质均存在于培养液中,而菌体破碎提取的胞内物不具有抑菌活性。本研究的结果与前人的研究结果相似,菌株LB-1的菌体超声破碎提取物无抑菌活性,但是其培养液能够明显抑制2种供试病原真菌的生长,说明菌株LB-1产生的抑菌物质可分泌到菌体细胞外的培养液中发挥其生防作用。菌株LB-1胞内物无明显的抑菌活性,可能是抑菌物质在胞内存在量极少难以检测到,也可能是抑菌物质在胞内产生后立即通过某种途径分泌到细胞外,这些问题还有待于进一步研究。
生防菌产生的抑菌物质可能是挥发性的,也可能是非挥发性的[13, 23]。Toghueo等[24]通过平板密封培养检测、乙酸乙酯萃取和琼脂孔检测发现,绿色木霉Trichoderma atroviridae能够产生抑制腐皮镰刀菌的挥发性和非挥发性抗菌物质,但Munjal等[25]从巨大芽孢杆菌Bacillus megaterium BP17中仅检测到了挥发性抑菌物质。本研究通过平板密封培养未检测到菌株LB-1产生挥发性抑菌物质,但其培养液有明显抑菌效果,表明菌株LB-1产生的是非挥发性抑菌物质。
盐析沉淀、酸沉淀和有机溶剂萃取是生防菌代谢活性物质提取的常见方法。盐析沉淀主要利用抑菌物质在饱和盐溶液中析出的特点分离蛋白类物质,酸沉淀主要用来分离大分子脂肽类物质,而有机溶剂萃取是利用物质在2种互不相溶的溶剂中分配系数或溶解度的差异从而对抑菌物质进行分离[7]。萃取生防菌抑菌物质的有机溶剂通常有正丁醇、乙酸乙酯、石油醚、三氯甲烷、二氯甲烷、正己烷、石油醚等,其中正丁醇极性最大[26]。本研究结果发现,菌株LB-1培养液中的抑菌物质可用有机溶剂萃取,而硫酸铵沉淀和盐酸沉淀不能获得菌株LB-1培养液中的抑菌物质,且有机溶剂萃取后的水相也没有明显抑菌活性,推测菌株LB-1产生的抑菌物质不属于蛋白和脂肽类,而且不溶于水。
毛壳菌是一类能够产生丰富代谢物质的生防菌类群,目前已从球毛壳中获得了抗菌物质chaetoviridin[27]、chaetomugilin[28]、chaetoglobosin[29-30]等,从角毛壳中获得了卵孢菌素[31]。本研究发现,近缘毛壳LB-1培养液正丁醇萃取物具有较强的抗菌活性,因此,需要对菌株LB-1培养液正丁醇萃取物进行分离、提纯和鉴定,以确定其活性成分和结构;同时还要研究该抑菌物质对植物病害的防治作用,从而为研究菌株LB-1生防菌剂防治植物病害奠定基础。
| [1] |
HUANG P M, WATTANACHAI P, KASEM S, et al. Efficacy of Chaetomium species as biological control agents against Phytophthora nicotianae root rot in citrus
[J]. Mycobiology, 2015, 43(3): 288-296. DOI:10.5941/MYCO.2015.43.3.288 (  0) 0) |
| [2] |
万 慧, 刘晓光, 曹荣花, 等. 螺旋毛壳ND35抗生素的产生及其在病害生物防治中的作用[J]. 植物保护学报, 2007, 34(1): 51-56. DOI:10.3321/j.issn:0577-7518.2007.01.010 (  0) 0) |
| [3] |
刘永亮, 尹成林, 田叶韩, 等. 拮抗真菌HTC的鉴定及其对辣椒疫病的生物防治潜力[J]. 植物保护学报, 2013, 40(5): 437-444. DOI:10.13802/j.cnki.zwbhxb.2013.05.008 (  0) 0) |
| [4] |
SOYTONG K, KANOKMEDHAKUL S, KUKONGVIRIYAPA V, et al. Application of Chaetomium species (Ketomium®) as a new broad spectrum biological fungicide for plant disease control: A review article
[J]. Fungal Diversity, 2001, 7: 1-15. (  0) 0) |
| [5] |
张 蕊, 田叶韩, 李 超, 等. 球毛壳菌ND35对黄瓜种子萌发和胚根生长的影响[J]. 北方园艺, 2020(23): 1-9. (  0) 0) |
| [6] |
FATIMA N, MUHAMMAD S A, KHAN I, et al. Chaetomium endophytes: A repository of pharmacologically active metabolites
[J]. Acta Physiologiae Plantarum, 2016, 38(6): 1-18. (  0) 0) |
| [7] |
梁海林, 童志武, 朱 笃. 球毛壳菌次级代谢产物及其生物活性研究进展[J]. 天然产物研究与开发, 2018, 30: 702-707. DOI:10.16333/j.1001-6880.2018.4.027 (  0) 0) |
| [8] |
印容, 高慧娟, 赵秀云. 球毛壳菌及其产生的鞘氨醇对油菜根肿病的室内生防作用[J]. 华中农业大学学报, 2016, 35(5): 58-62. DOI:10.13300/j.cnki.hnlkxb.2016.05.029 (  0) 0) |
| [9] |
SHYLAJA G, SASIKUMAR K, SATHIAVELU A. Antimycobacterial potential of resorcinol type lipid isolated from Chaetomium cupreum, an endophytic fungus from Mussaenda luteola
[J]. Bangladesh Journal of Pharmacology, 2018, 13: 114-119. DOI:10.3329/bjp.v13i2.34860 (  0) 0) |
| [10] |
GUO Q F, YIN Z H, ZHANG J J, et al. Chaetomadrasins A and B, two new cytotoxic cytochalasans from desert soil-derived fungus Chaetomium madrasense 375
[J]. Molecules, 2019, 24(18): 3240-3249. DOI:10.3390/molecules24183240 (  0) 0) |
| [11] |
赵德立, 曾林子, 李 晖, 等. 多粘芽孢杆菌JW-725抗菌活性物质及其发酵条件的初步研究[J]. 植物保护, 2006, 32(1): 47-50. DOI:10.3969/j.issn.0529-1542.2006.01.012 (  0) 0) |
| [12] |
梁建根, 吴吉安, 竺利红, 等. 生防菌BH-2发酵液中抑菌成分的定位及提取研究[J]. 中国农学通报, 2007, 23(11): 324-327. DOI:10.3969/j.issn.1000-6850.2007.11.070 (  0) 0) |
| [13] |
LANDUM M C, DO ROSÁRIO FÉLIX M, ALHO J, et al. Antagonistic activity of fungi of Olea europaea L. against Colletotrichum acutatum
[J]. Microbiological Research, 2016, 183: 100-108. DOI:10.1016/j.micres.2015.12.001 (  0) 0) |
| [14] |
SILVA M, PEREIRA A, TEIXEIRA D, et al. Combined use of NMR, LC-ESI-MS and antifungal tests for rapid detection of bioactive lipopeptides produced by Bacillus
[J]. Advances in Microbiology, 2016, 6: 788-796. DOI:10.4236/aim.2016.610077 (  0) 0) |
| [15] |
许乐, 王子强, 张 爽, 等. 丹参根腐病拮抗细菌筛选、鉴定及生防机理研究[J]. 中国生物防治学报, 2021, 37(4): 846-854. DOI:10.16409/j.cnki.2095-039x.2021.04.011 (  0) 0) |
| [16] |
杨廷雅, 孙 亮, 周婷婷, 等. 短短芽孢杆菌Brevibacillus brevs HAB-5主要抑菌活性成分的分析及其特性研究
[J]. 中国生物防治学报, 2021, 30(2): 222-231. (  0) 0) |
| [17] |
PHONG N H, PONGNAK W, SOYTONG K. Antifungal activities of Chaetomium spp. against Fusarium wilt of tea
[J]. Plant Protection Science, 2016, 52(1): 10-17. DOI:10.17221/34/2015-PPS (  0) 0) |
| [18] |
YAN W, CAO L L, ZHANG Y Y, et al. New metabolites from endophytic fungus Chaetomium globosum CDW7
[J]. Molecules, 2018, 23(11): 1-7. (  0) 0) |
| [19] |
刘彩云, 季洪亮, 王 瑞, 等. 生防菌株LB-1对几种常见植物病原真菌的拮抗作用及其生长适应性分析[J]. 植物保护学报, 2018, 45(2): 332-339. (  0) 0) |
| [20] |
罗 琳, 周泠璇, 刘 娅. 毕赤酵母G5拮抗葡萄灰霉病机理初探[J]. 生物技术通报, 2017, 33(9): 210-215. (  0) 0) |
| [21] |
周 瑚, 邹秋霞, 胡 玲, 等. 特基拉芽孢杆菌JN-369的分离鉴定及其抑菌物质分析[J]. 农药学学报, 2019, 21(1): 52-58. (  0) 0) |
| [22] |
马桂珍, 吴少杰, 付泓润, 等. 海洋放线菌BM-2菌株抗真菌活性物质的分离纯化与结构鉴定[J]. 中国生物防治学报, 2014, 30(3): 393-401. (  0) 0) |
| [23] |
JUNIOR W J F L, BOVO B, NADAI C, et al. Biocontrol ability and action mechanism of Starmerella bacillaris (Synonym Candida zemplinina) isolated from wine musts against gray mold disease agent Botrytis cinerea on grape and their effects on alcoholic fermentation
[J]. Frontiers in Microbiology, 2016, 7: 1-12. (  0) 0) |
| [24] |
TOGHUEO R M K, EKE P, ZABALGOGEAZCOA I, et al. Biocontrol and growth enhancement potential of two endophytic Trichoderma spp. from Terminalia catappa against the causative agent of common bean root rot (Fusarium solani)
[J]. Biological Control, 2016, 96: 8-20. DOI:10.1016/j.biocontrol.2016.01.008 (  0) 0) |
| [25] |
MUNJAL V, NADAKKAKATH A V, SHEORAN N, et al. Genotyping and identification of broad spectrum antimicrobial volatiles in black pepper root endophytic biocontrol agent, Bacillus megaterium BP17
[J]. Biological Control, 2016, 92: 66-76. DOI:10.1016/j.biocontrol.2015.09.005 (  0) 0) |
| [26] |
MCMULLIN D R, SUMARAH M W, BLACKWELL B A, et al. New azaphilones from Chaetomium globosum isolated from the built environment
[J]. Tetrahedron Letters, 2013, 54: 568-572. DOI:10.1016/j.tetlet.2012.11.084 (  0) 0) |
| [27] |
PARK J H, CHOI G J, JANG K S, et al. Antifungal activity against plant pathogenic fungi of chaetoviridins isolated from Chaetomium globosum
[J]. FEMS Microbiology Letters, 2005, 252(2): 309-313. DOI:10.1016/j.femsle.2005.09.013 (  0) 0) |
| [28] |
YAMADA T, MUROGA Y, JINNO M, et al. New class azaphilone produced by a marine fish-derived Chaetomium globosum: The stereochemistry and biological activities
[J]. Bioorganic and Medicinal Chemistry, 2011, 19(13): 4106-4113. DOI:10.1016/j.bmc.2011.05.008 (  0) 0) |
| [29] |
JIAO W X, FENG Y J, BLUNT J W, et al. Chaetoglobosins Q, R and T, three further new metabolites form Chaetomium globosum
[J]. Journal of Natural Products, 2004, 67(10): 1722-1725. DOI:10.1021/np030460g (  0) 0) |
| [30] |
ZHENG Q C, KONG M Z, ZHAO Q, et al. Chaetoglobosin Y, a new cytochalasan from Chaetomium globosum
[J]. Fitoterapia, 2014, 93: 126-131. DOI:10.1016/j.fitote.2013.12.022 (  0) 0) |
| [31] |
何海清, 钟 娟, 周金燕, 等. 角毛壳菌CH-1产生的抗真菌活性化合物的纯化和鉴定[J]. 中国生物防治学报, 2015, 31(4): 592-597. (  0) 0) |
 2023, Vol. 44
2023, Vol. 44

